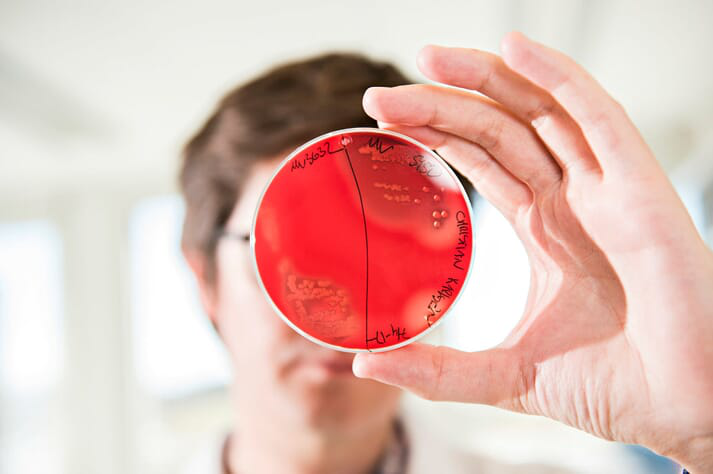

挪威NOFIMA研究集团的一些研究微生物群落的科学家正在致力于揭示鱼类与其微生物之间复杂的相互关系,旨在改善养殖鱼类的健康状况。
微生物群系:自成体系的系统
包括鱼类在内的各种动物体内寄生或共生的数以万亿的微生物被统称为微生物群落。这些复杂的微生物群落之间相互作用,与宿主和宿主生存的环境也相互作用,它们被称为微生物群系。
在挪威NOFIMA研究集团,一些科学家在合作探索微生物群系对水产养殖物种进食的影响。目前,合作研究聚焦于探究微生物群系对鱼类肠道系统的影响。
为什么要研究鱼类微生物群系?
生活在动物肠道中的高度复杂且相互影响的微生物群落被称为肠道菌群。宿主整体的健康情况与微生物群的稳定及快速复原能力息息相关。科学家们正在努力研究人类和其他陆生动物中,宿主和微生物之间以及微生物自身之间的相互作用。如今,我们知道肠道菌群在维持宿主肠道稳定以及代谢和免疫功能方面起着至关重要的作用。与人类以及其他动物一样,鱼类等低等脊椎动物的肠道菌群也有助于维持宿主机体免疫平衡、消化正常和营养健康。
鱼类微生物群落是复杂多样的,包括原生生物、细菌、古菌、真菌和病毒,由一些与宿主自身相关的因素形成,如食物摄入、年龄、生活的地理位置、水压、遗传因素和药物。在鱼类肠道的微生物群落中,细菌数量最多,是最主要的微生物,它们与肠道粘膜(胃肠道的内层)关系密切,并赋予健康生物个体实质性的功能——它们共存于机体中,富含多种功能,有助于维生素、氨基酸和细菌代谢产物的产生或合成。
挪威NOFIMA研究集团研究鱼类微生物群系的策略
目前,人们对微生物群系研究的许多方面还知之甚少,因为研究人员不确定鱼类体内的微生物群系在何时、何地以何种方式产生。我们需要了解这些信息,以便最大限度地发挥这一新领域在水产养殖方面的潜力。微生物群系研究是跨学科进行的,而挪威NOFIMA研究集团有一个特殊的优势,即其研究领域涉及多个学科,包括鱼类健康、营养、遗传学、生产生物学和食品加工等,只有这些跨学科的研究共同进行才能解开这些微生物群系研究中的未解之谜。
以往的研究大多集中在鱼类微生物群落的结构上,忽视鱼类肠道菌群的巨大潜在功能。在挪威NOFIMA研究集团,我们开展的研究的部分目标是了解和研究微生物群落如何在不同的生长环境中协同工作(例如微生物群落对细菌过滤活动的影响)以及它如何与宿主组织间相互作用(即它在营养转化、维持健康和避免疾病中的作用)。此外,我们的另一些目标是确定这些微生物在宿主体内的关键功能,这可能对水产养殖业的未来发展有巨大价值。而且,鱼类疾病是水产养殖业面临的最大挑战之一,所以在我们致力于解决这些问题时,首先要做的,就是确定引起疾病的单一致病微生物。相比之下,在挪威NOFIMA研究集团开展的研究可以让我们另辟蹊径,通过鉴定其余的微生物群落,来确定它们是否能对病原体产生某种抗体。

这些研究旨在深入了解微生物的作用和抗病反应机制以应对不断恶化的皮肤健康问题。近年来,鱼类食物摄入研究表明,微生物群系成分的变化主要是由某些细菌引起的,但这类细菌在研究中经常处于不同的形态,而且,在与外部微生物群系频繁作用的情况下,(例如与来自周围水域或生活在同一个养殖池塘中的其他鱼类的各种微生物接触)也会发生变化。目前,我们的研究仍面临着某些限制条件,比如我们无法测量鱼类肠道中微生物细胞的绝对数量,因此,挪威NOFIMA研究集团正在研究确定宿主微生物相互作用的潜在机制。
一般来说,肠道内的大多数厌氧细菌对于不易消化的复杂基质具有惊人的发酵能力,这种发酵过程会产生细菌代谢产物,如短链脂肪酸(SCFAs)和一些其他气体。醋酸纤维素、丁酸盐和丙酸盐是研究最多的短链脂肪酸。这些短链脂肪酸因其对人类和养殖动物肠道健康有益而备受关注。获取短链脂肪酸方面的相关知识对于改善养殖鱼类的健康非常有益,但目前我们对这方面所了解的信息知之甚少。
挪威NOFIMA研究集团的科学家们正致力于利用新的分子技术(如下一代测序技术)和色谱技术(如气相色谱分析)来研究鱼类与其肠道菌落之间的相互联系。我们之前所进行的实验已发现大西洋幼鲑在海洋中迁移时,会根据季节和地点改变自身的微生物群落。此外,我们的研究结果还表明,主要的短链脂肪酸浓度会随着鱼类食物摄入模式的不同而改变。目前,我们正在努力研究主要的短链脂肪酸和鱼类之间的相互作用。
我们还对大西洋鲑鱼的皮肤和肠道微生物群落进行了一次大规模的微生物调查,对比了北半球野生鲑鱼和养殖鲑鱼的不同生命阶段。我们的目标是调查引起微生物群落变化的原因,并确定哪些微生物的存在对宿主的健康是长久必要的,而哪些又只是短暂性存在的。挪威NOFIMA研究集团的相关研究也集中在影响养殖鱼类微生物群落的诱因和转变上。
此外,今年我们希望通过核心研究人员对于功能获得性饮食肠道菌群的研究,来获取一些关于肠道宿主微生物群落关系的新进展。研究人员将通过鱼类宿主系统功能的不同机制,继续探索鱼类食物摄入对于微生物群落组成成分和功能的影响。
我们正在进行的研究得出了一项关键结论,即人们应该明白,对于我们如今所养殖的每一条鱼,我们不仅养育了鱼类本身,也养育了包含其中的数万亿种其它微生物。因此,想要培养和维持健康的鱼类肠道菌落,就必须从根本上了解鱼类相关微生物群落的多样性和组成特征及其对鱼类生长和健康的影响。
鱼类肠道菌群的研究随着最新测序技术的发展向前迈进了一大步。然而,有关鱼类肠道菌落的功能以及细菌代谢产物与鱼类之间的相互作用应该成为研究重点,以便制定有效的策略,使鱼类远离病原体,健康成长。
编译:何晴
审校:邹磊磊
新闻来源:TheFishSite网